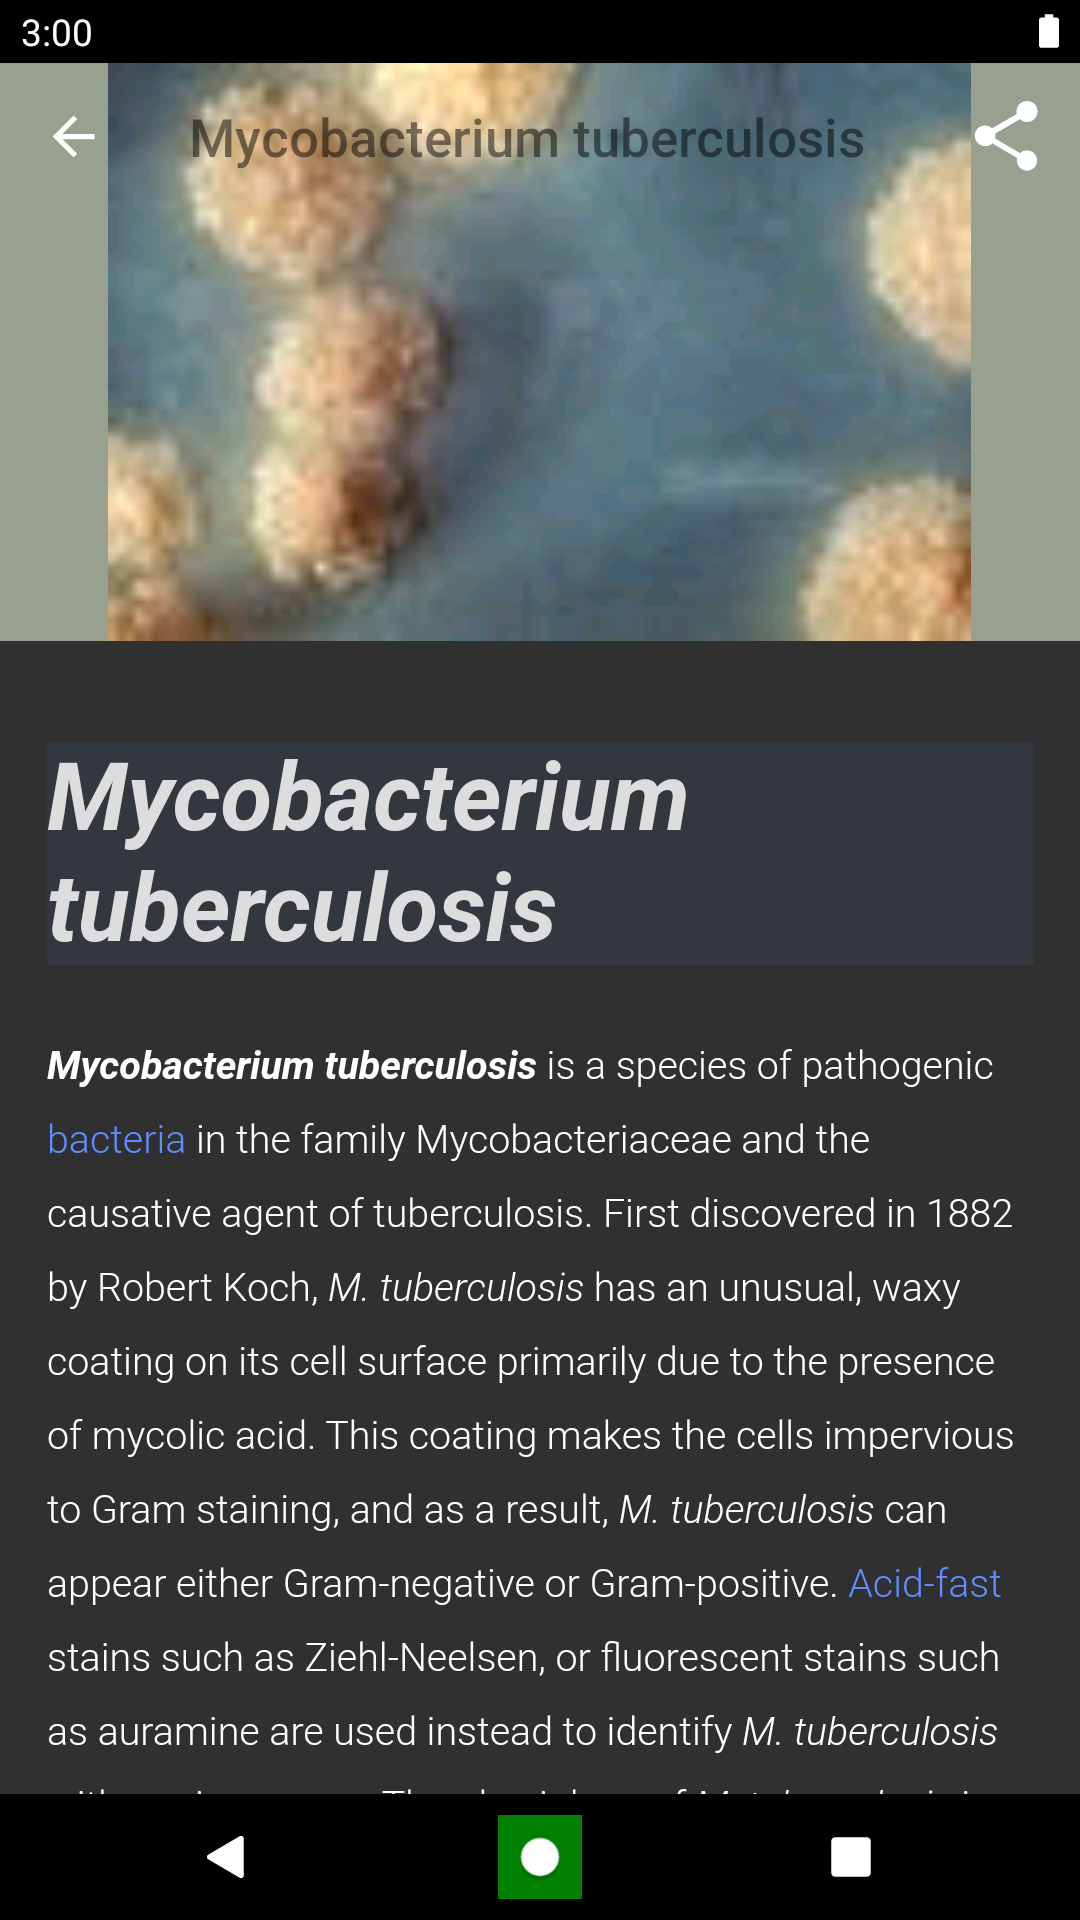
Bacteria: Types, Infections Screenshot 2

Bacteria: Types, Infections is one of the best apps. Bacteria: Types, Infections offers in-depth insights into infectious diseases, antibiotic resistance, diagnostic techniques, and emerging infections, empowering users to stay informed and make educated decisions. The user-friendly interface, offline accessibility, note-taking, bookmarking, and PDF export features enhance the overall learning experience, ensuring that users can customize their studying journey according to their individual needs. "Bacteria: Types, Infections" is an invaluable tool for anyone looking to explore the intriguing world of microbiology and healthcare.
Features of Bacteria: Types, Infections:
Comprehensive Bacteria Database: Access a wide range of bacteria types for identification and understanding.
In-Depth Infection Insights: Explore detailed information on various infectious diseases, symptoms, and treatment options.
Visual Learning: Engage with captivating visuals that enhance your learning experience.
Offline Accessibility: Study anytime, anywhere with offline access to all materials.
Updates and Research: Stay current with information on emerging infections and recent research findings.
User-Friendly Interface: Navigate the app easily with a simple and intuitive design.
FAQs of Bacteria: Types, Infections:
Can I access the app offline?
Yes, you can access all materials offline for uninterrupted studying.
Is the app user-friendly?
Yes, the app has a straightforward interface designed for easy navigation.
How often is the content updated?
The app provides prompt updates on new bacterial strains and relevant outbreaks.
Can I save important sections for later?
Yes, you can bookmark and make notes on important sections for future reference.
Conclusion:
Embark on a journey of knowledge discovery with "Bacteria: Types, Infections." Whether you're a student, educator, or healthcare professional, this app offers valuable information to deepen your understanding of bacteria and infectious diseases. Download the app today and start exploring the microbial world to make well-informed decisions for a healthier future.